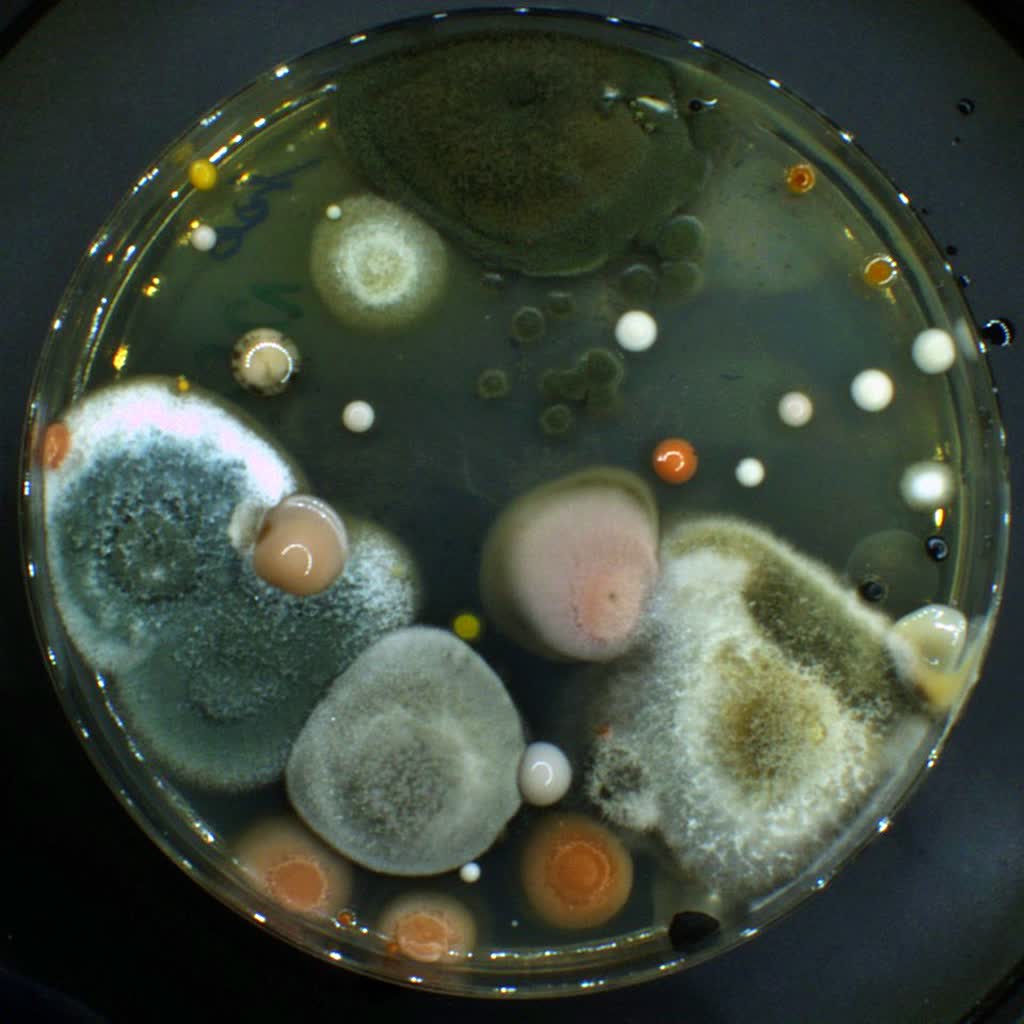
Lubelscy naukowcy przebadali automaty paczkowe. Co na nich znaleźli? 2 media (1).jpg

Naukowcy z Uniwersytetu Medycznego w Lublinie zbadali, jakie bakterie występują na automatach paczkowych. Sprawdzili 64 takich urządzeń rozmieszczonych w 16 dzielnicach miasta. Największe zanieczyszczenie mikrobiologiczne wykryto na Czubach Północnych.
CZYTAJ: Fotograficzna podróż w czasie. Pomoże w niej kazimierski fotoplastikon [ZDJĘCIA]
O szczegółach badania opowiedziała dr Martyna Kasela, opiekun Studenckiego Koła Naukowego mikroGram przy Katedrze i Zakładzie Mikrobiologii Farmaceutycznej UM w Lublinie. Zwróciła uwagę, że Polska znajduje się na pierwszym miejscu pod względem liczby automatów paczkowych w Unii Europejskiej oraz na drugiej pozycji na świecie, zaraz po Chinach.
– Automaty paczkowe cieszą się w ostatnich latach bardzo dużą popularnością. Do tej pory nikt w Polsce nie podjął się próby przebadania tych urządzeń pod kątem drobnoustrojów. Przede wszystkim chcieliśmy sprawdzić liczbę bakterii i grzybów występujących na takich sprzętach – podkreśliła ekspertka.
Przebadano 64 automaty paczkowe
Członkowie koła naukowego wytypowali do badań 64 automaty paczkowe z 16 dzielnic Lublina, w których zameldowanych jest ponad 10 tys. mieszkańców. Pobrali próbki wymazów i odcisków z ekranów dotykowych i przycisków urządzeń, które następnie poddano analizie w laboratorium.
Gdzie wykryto największa zanieczyszczenie?
Z przeprowadzonych badań wynika, że najwyższe zanieczyszczenie mikrobiologiczne wykryto na urządzeniach w dzielnicach: Czuby Północne, Czuby Południowe oraz Dziesiąta, a najniższe na Bronowicach, Czechowie Północnym oraz Tatarach.
– Dwie pierwsze dzielnice zamieszkuje największa liczba osób, potencjalnych użytkowników urządzeń paczkowych. Z tego powodu nasza analiza wykazała korelację między poziomem zanieczyszczenia a liczbą zameldowanych mieszkańców – sprecyzowała dr Martyna Kasela.
Co znaleziono na automatach paczkowych?
Zaznaczyła, że większość to były niegroźne dla człowieka bakterie i grzyby pochodzące z naturalnego środowiska miejskiego, które osiadają na urządzeniach wraz z kurzem i pyłkami roślin. Chodzi np. o bakterie należące do tlenowych laseczek z rodzajów Bacillus czy Paenibacillus, naturalnie występujące w powietrzu atmosferycznym.
Badacze stwierdzili również obecność gronkowców, czyli bakterii pochodzących ze skóry człowieka, które automatycznie zostały przeniesione poprzez dotyk na ekrany automatów paczkowych.
„Wykryliśmy także obecność tzw. bakterii oportunistycznych, czyli takich, które mogą wywołać zakażenia u osób z osłabionym układem odpornościowym. Były to bakterie: Escherichia coli – pałeczka okrężnicy oraz Bacillus cereus, mogące wywołać zatrucia pokarmowe” – wyjaśniła badaczka.
Co dalej?
W dalszych badaniach członkowie koła naukowego zamierzają sprawdzić oporność tych drobnoustrojów na antybiotyki.
Ekspertka podkreśliła znaczenie mycia rąk w codziennej profilaktyce zakażeń. – Kluczowy jest czas – ok. 30 sekund oraz mycie przestrzeni często pomijanych, tj. między palcami i pod paznokciami. Ważne też, aby nie dotykać ust i oczu brudnymi dłońmi – zaapelowała dr Kasela.
Szczegółowe wyniki badań opublikowano na stronie internetowej.
Wydarzenie zostało zrealizowane przy wsparciu finansowym Gminy Lublin, w ramach Programu Lublin Akademicki pt. „Automaty paczkowe jako źródło drobnoustrojów w przestrzeni publicznej”.
PAP / RL / opr. AKos
Fot. sites.google.com/view/automatypaczkowe





![W dwa dni zatrzymali 128 osób. Udana akcja lubelskiej policji [ZDJĘCIA] 4 EAttachments927960240344d3132b78d65d59c95c83eb72676 xl](https://radio.lublin.pl/wp-content/uploads/2026/01/EAttachments927960240344d3132b78d65d59c95c83eb72676_xl-350x250.jpg)


![Fotograficznymi śladami Miłosza. Wyjątkowa wystawa otwarta [ZDJĘCIA] 7 EAttachments92799506915c2e117adf615dd8e6e47291997fd xl](https://radio.lublin.pl/wp-content/uploads/2026/01/EAttachments92799506915c2e117adf615dd8e6e47291997fd_xl-350x250.jpg)




